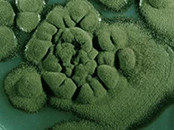

Αεροαλλεργιογόνα είναι τα αλλεργιογόνα του εξωτερικού και εσωτερικού περιβάλλοντος τα οποία ευθύνονται για πολλές από τις αλλεργίες του αναπνευστικού συστήματος όπως η αλλεργική ρινοεπιπεφυκίτιδα και το εξωγενές βρογχικό άσθμα. Τα σημαντικότερα εξ αυτών είναι τα ακάρεα της οικιακής σκόνης, οι γύρεις και οι μύκητες.
Οι μύκητες είναι ε υκαρυωτικοί οργανισμοί, έχουν άκαμπτα κυτταρικά τοιχώματα και στερούνται χλωροφύλλης. Έχουν αποδεδειγμένα, ενοχοποιηθεί για την πρόκληση αλλεργικής ρινίτιδας και άσθματος, αλλεργικής βρογχοπνευμονικής ασπεργίλλωσης και πνευμονίτιδας εξ υπερευαισθησίας. Τα σπόρια ορισμένων μυκήτων είναι εκ φύσεως αερομεταφερόμενα Αντίθετα, η πλειονότητα των σαπροφυτικών μυκήτων εξαρτώνται για την μεταφορά τους από την κίνηση του αέρος ή από άλλες διαταραχές του περιβάλλοντος όπως οι κινήσεις των ζώων και των αρθρόποδων, η κίνηση του αέρος ή οι ανθρώπινες δραστηριότητες. Η διείσδυσή τους από το εξωτερικό στο εσωτερικό περιβάλλον, εξαρτάται από τον αερισμό και τις διαρροές στην κατασκευή του σπιτιού. Όταν τα παράθυρα είναι ανοικτά, τα επίπεδα στο εσωτερικό είναι περίπου το 40% εκείνων του εξωτερικού περιβάλλοντος. Σε κλειστούς χώρους τα επίπεδά τους κυμαίνονται από 5 έως 10% των εξωτερικών και εφ’ όσον ελλείπουν οι συνθήκες εκείνες οι οποίες είναι δυνατόν να αυξήσουν, προσωρινά, τις συγκεντρώσεις τους.
υκαρυωτικοί οργανισμοί, έχουν άκαμπτα κυτταρικά τοιχώματα και στερούνται χλωροφύλλης. Έχουν αποδεδειγμένα, ενοχοποιηθεί για την πρόκληση αλλεργικής ρινίτιδας και άσθματος, αλλεργικής βρογχοπνευμονικής ασπεργίλλωσης και πνευμονίτιδας εξ υπερευαισθησίας. Τα σπόρια ορισμένων μυκήτων είναι εκ φύσεως αερομεταφερόμενα Αντίθετα, η πλειονότητα των σαπροφυτικών μυκήτων εξαρτώνται για την μεταφορά τους από την κίνηση του αέρος ή από άλλες διαταραχές του περιβάλλοντος όπως οι κινήσεις των ζώων και των αρθρόποδων, η κίνηση του αέρος ή οι ανθρώπινες δραστηριότητες. Η διείσδυσή τους από το εξωτερικό στο εσωτερικό περιβάλλον, εξαρτάται από τον αερισμό και τις διαρροές στην κατασκευή του σπιτιού. Όταν τα παράθυρα είναι ανοικτά, τα επίπεδα στο εσωτερικό είναι περίπου το 40% εκείνων του εξωτερικού περιβάλλοντος. Σε κλειστούς χώρους τα επίπεδά τους κυμαίνονται από 5 έως 10% των εξωτερικών και εφ’ όσον ελλείπουν οι συνθήκες εκείνες οι οποίες είναι δυνατόν να αυξήσουν, προσωρινά, τις συγκεντρώσεις τους. Οι μύκητες για να αναπτυχθούν στο εσωτερικό περιβάλλον απαιτείται θερμοκρασία 18-24ο C και σχετική υγρασία περίπου 60%. Οι σαπροφυτικοί μύκητες δημιουργούν αποικίες σε πολλά οργανικά υποστρώματα όπως υφάσματα, χαρτιά, δέρματα, χρώματα ή σάπωνες. Ο καθοριστικός παράγων στο εσωτερικό περιβάλλον είναι συνήθως το νερό. Όταν μια οργανική ουσία υγραίνεται, αναπτύσσονται μύκητες. Η διατήρηση του εσωτερικού του σπιτιού, στεγνού και της σχετικής υγρασίας σε επίπεδα κάτω του 50% είναι η πλέον σίγουρη μέθοδος αποτροπής της εγκαταστάσεως και περαιτέρω αναπτύξεως των μυκήτων.
Οι μύκητες για να αναπτυχθούν στο εσωτερικό περιβάλλον απαιτείται θερμοκρασία 18-24ο C και σχετική υγρασία περίπου 60%. Οι σαπροφυτικοί μύκητες δημιουργούν αποικίες σε πολλά οργανικά υποστρώματα όπως υφάσματα, χαρτιά, δέρματα, χρώματα ή σάπωνες. Ο καθοριστικός παράγων στο εσωτερικό περιβάλλον είναι συνήθως το νερό. Όταν μια οργανική ουσία υγραίνεται, αναπτύσσονται μύκητες. Η διατήρηση του εσωτερικού του σπιτιού, στεγνού και της σχετικής υγρασίας σε επίπεδα κάτω του 50% είναι η πλέον σίγουρη μέθοδος αποτροπής της εγκαταστάσεως και περαιτέρω αναπτύξεως των μυκήτων.
Mύκητας Alternaria alternata

Είναι είδος εξαιρετικά διαδεδομένο σε όλο τον κόσμο και απαντάται σε πολλά φυτά, στο έδαφος, στις αποθήκες καλαμποκιού, στα σάπια ξύλα, στις φωλιές των πουλιών και σε είδη ρουχισμού. Οι μαύρες κηλίδες στις ντομάτες μπορεί να οφείλονται στον μύκητα Alternaria ενώ συχνά ανευρίσκεται στα πλαίσια των παραθύρων. Θεωρείται μύκητας του εξωτερικού περιβάλλοντος και εμφανίζεται όταν ο καιρός είναι ζεστός με θερμοκρασία >30o C.
Μύκητας Cladosporium herbarum
Είναι ο συχνότερα απαντώμενος αερομεταφερόμενος μύκητας στην ατμόσφαιρα και έχει παγκόσμια κατανομή. Η περιεκτικότητα των εσωτερικών χώρων συμβαδίζει με εκείνη των εξωτερικών. Ανάλογα με το κλίμα και τη θερμοκρασία που πρέπει να είναι 18-28ο C, εμφανίζεται τον Μάιο και κυρίως την περίοδο Ιουλίου-Oκτωβρίου. Απαντάται στα σάπια φύλλα και φυτά, στο χώμα και στα δημητριακά, τα αγγούρια, τις ντομάτες, τα ροδάκινα κ.ά. Συχνά ανευρίσκεται στα ακάθαρτα ψυγεία, στα υγρά πλαίσια των παραθύρων, σε κακώς αεριζόμενα σπίτια και σε σπίτια με υγρασία. Περιστασιακά έχει ανιχνευθεί σε ντεπόζιτα καυσίμων, κρέμες προσώπου, χρώματα και υφάσματα.
αεριζόμενα σπίτια και σε σπίτια με υγρασία. Περιστασιακά έχει ανιχνευθεί σε ντεπόζιτα καυσίμων, κρέμες προσώπου, χρώματα και υφάσματα.
Μύκητας Aspergillus fumigatus
Έχει παγκοσμία κατανομή, για να αναπτυχθεί χρειάζεται θερμοκρασίες 12 έως 57ο C και μεγάλη υγρασία και θεωρείται ως σημαντικός μύκητας των εσωτερικών χώρων. Αναπτύσσεται στα σκουπίδια, στα πεύκα και στα φυτά του καφέ, στα κρεμμύδια, το ρύζι, τα δημητριακά, τις ρίζες των φραουλών, στα περιττώματα των πουλιών, στις αποθήκεςπατατών, στα λιπάσματα κ.ά.
Mύκητας Penicillium notatum
Πρόκειται για μύκητα ο οποίος παράγει πενικιλίνη και έχει παγκόσμια κατανομή. Ανευρίσκεται στο έδαφος και στα δάση και τα λιβάδια των περιοχών με εύκρατο κλίμα. Είναι διαδεδομένος στα αμπέλια και τις φυτείες εσπεριδοειδών αλλά και στα λάχανα, τις πευκοβελόνες, τις αποθήκες δημητριακών, τον υγρό σανό, τις φωλιές των πουλιών, τα σταφύλια, τους ξηρούς καρπούς, τα αποξηραμένα φρούτα και τους φρουτοχυμούς. Στο εσωτερικό, υπάρχει στη μούχλα που αναπτύσσεται στο ψωμί, τα εσπεριδοειδή, τα μήλα κλπ. Συχνά απαντάται και στα κελάρια που φυλάσσονται κρασιά. Οι μέγιστες συγκεντρώσεις του μύκητα Penicillium παρατηρούνται τον Χειμώνα και την Άνοιξη.

